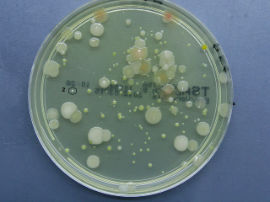

Labor
Mit einem hochauflösenden Mikroskop, sind wir nicht nur in der Lage Ektoparasiten und Endoparasiten zu erkennen, sondern auch Bakterien und diese grob anhand ihres Erscheinungsbildes einzuordnen.
Eine Kamera ermöglicht es, die gefundenen Parasiten und Bakterien in unserer Datenbank zu archivieren, so dass wir immer wieder schnell darauf zurückgreifen können, um schnellstmöglich die richtige Entscheidung für eine eventuelle Behandlung treffen zu können.
Ektoparasiten kommen in der Regel immer in einer kleinen Menge als "blinde Passagiere" mit den Tieren mit. In der Herkunft, gleich ob Nachzuchten oder als Wildentnahmen, kamen die Tiere problemlos mit diesen Parasiten und Schwächeparasiten klar. Durch den Transport und die damit verbundene Stresssituation sind die Tiere nicht mehr in der Lage, diese Parasiten entsprechend abzuwehren und diese können sich nun ungehindert an den Tieren vermehren und diese schwächen. Ektoparasiten sind relativ einfach zu finden und unter einem geeigneten Mikroskop zu identifizieren. Die Behandlung ist auch relativ einfach und gelingt uns in der Regel innerhalb der ersten 5 -14 Tage nach Ankunft der Tiere.
Bakterien kommen ebenfalls bei allen Tieren vor und die Tiere haben es mit Hilfe ihres Immunsystems gelernt, mit diesen Bakterien klarzukommen. Das heißt, das Immunsystem der Tiere hat gegen diese Bakterien Antikörper produziert, die diese Bakterien nur in einer kleinen, für das Tier unproblematischen Menge im Körper der Tiere vorkommen lassen.
Durch eine entstehende Stresssituation, die nachweislich durch das Fangen und den Transport der Tiere entstehen kann, kann das Immunsystem eingeschränkt werden und nicht genügend Antikörper produzieren. Das kann dazu führen, dass sich die Bakterien derart vermehren können (bei manchen Arten eine Verdopplung innerhalb von 20 Minuten), dass die Ausscheidungsprodukte der Bakterien die Tiere vergiften können. Das Ganze kann innerhalb von 2 - 5 Tagen nach dem Transport passieren.
Unser Ziel ist es allerdings, Antibiotika nur im äußersten Notfall einzusetzen und darum legen wir deutlich mehr Wert darauf, unsere Tiere optimal einzugewöhnen. Wir setzen daher eher auf eine Keimreduzierung sowie eine bestmögliche Stimulation des Immunsystems der Tiere. Unsere sorgfältige und regelmäßige Überprüfung der Mikroorganismen in unserer Anlage sowie die Überprüfung der einzelnen Bakterienarten auf deren Antibiotikaresistenzen zeigen uns, dass in einem Notfall fast alle verfügbaren Antibiotika gegen die bei uns nachgewiesenen Bakterien funktionstüchtig sind. Das wiederum bestätigt uns, dass unsere Vorgehensweise in unserer Anlage für unsere Kunden, Mitarbeiter, Tiere und die Umwelt das Optimum darstellt.
Anhand der folgenden Fotoserie, die innerhalb von 14 Tagen in derselben Anlage gemacht wurde, können Sie erkennen, wie sich die Bakterienfauna ständig verändert. Auch hier unterliegen die Mikroorganismen, genau wie in der Natur, einem ständigen Kampf ums Überleben. Die Menge der einzelnen Arten im jeweiligen Lebensraum kann sich, durch die schnelle Generationszeit von bis zu einer Verdopplung innerhalb von 20 Minuten und den sich ständig wechselnden Einflüssen in diesem Umfeld, ständig ändern. Die Tiere in diesem System waren während der ganzen Zeit bei bester Gesundheit, obwohl Bakterien nachgewiesen wurden, die durchaus in der Lage sind, gesundheitliche Probleme bei den Tieren zu verursachen. Das wiederum spiegelt wider, dass ein Tier mit einem intakten Immunsystem jederzeit in der Lage ist, auch mit pathogenen Keimen klarzukommen.
Die Menge und die Arten der hier dargestellten Mikroorganismen finden Sie auch in einer ähnlichen Form in Ihrem Aquarium. Aber keine Angst, diese Arten sind in der Regel in einem intakten Aquarium absolut unproblematisch für Ihre Tiere und vor allem auch für Sie.
Typ 1 Staphylokokken (Koagulase-negative), Typ 2 Micrococcus sp., Typ 3 Shewanella putrefaciens, Typ 4 Oligella ureolytica, Typ 5 Flavobacter sp., Typ 6 Flavobacter sp., Typ 7 Aeromonaden (bewegliche), Typ 8 Micrococcus sp., Typ 9 Staphylokokken (Koagulase-negative), Typ 10 Bazillen (aerobe), Typ 11 Staphylokokken (Koagulase-negative), Typ 12 Bazillen (aerobe), Typ 13 Micrococcus sp., Typ 14 Flavobacter sp., Typ 15 Micrococcus sp., Typ 16 Shewanella putrefaciens, Typ 17 Flavobacter sp., Typ 18 Flavobacter sp., Typ 19 Aeromonaden (bewegliche), Typ 20 Bazillen (aerobe), Typ 21 Staphylokokken (alpha-haemolysierende)
Ein professionelles Photometer rundet unsere Möglichkeiten, optimale Wasserverhältnisse zu halten, ab.